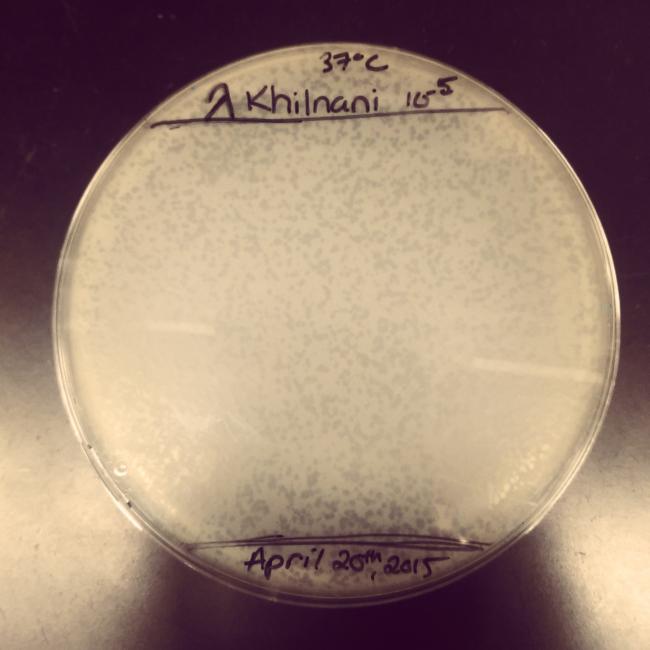

Please wait...
About This Project
Bacteriophages (phages) are bacterial viruses that are very safe to humans, and can be manipulated both on the genetic and physical levels.
Our lab specializes in the engineering of phage to treat human diseases. We have made a phage that can target key immune cells in the body (dendritic cells) to deliver DNA that encodes a safe vaccine that can stimulate powerful immunity against Human Immunodeficiency Virus (HIV), the causative agent of AIDS.
Our lab specializes in the engineering of phage to treat human diseases. We have made a phage that can target key immune cells in the body (dendritic cells) to deliver DNA that encodes a safe vaccine that can stimulate powerful immunity against Human Immunodeficiency Virus (HIV), the causative agent of AIDS.

Browse Other Projects on Experiment
Related Projects
Highly-sensitive, real-time enzyme methane oxidation rate measurements using an electrochemical assay
A low-cost, rapid, and highly sensitive assay is needed to measure methane gas oxidation rates by methane...
Engineering of a suction cup stethoscope for non-invasive monitoring of physiological sounds in baleen whales
Baleen whales are large-bodied predators that, despite their critical role in marine ecosystems, our understanding...
Building a better fish: Engineering fish for smarter aquaculture
What if we built a better fish instead of depleting wild fisheries? Natural stocks can’t keep up with demand...